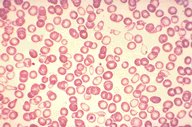

Description
This low power view of a peripheral blood smear is
seen with Wright's stain. It shows a double
population of red cells. Some of these blood
cells are normal, others are smaller and
hypochromic, still others are macrocytic. Modest
anisocytosis and poikilocytosis are present.
|
|
Click on this image
to enlarge it, then
on Back botton
in the Netscape Menu
to shrink it back down



|